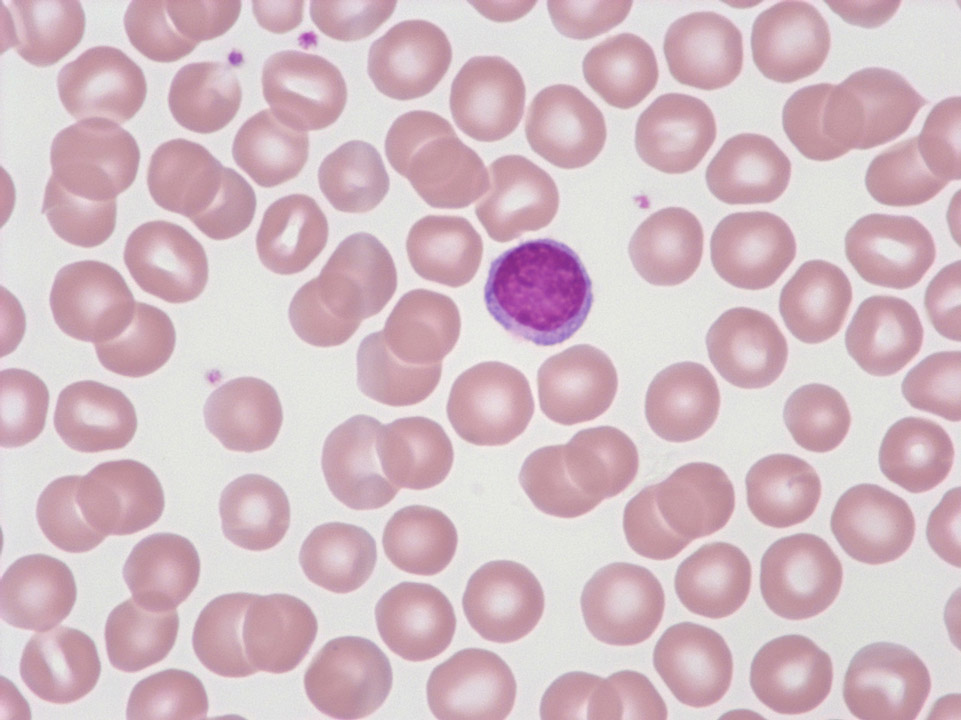

Лимфоциты — ключевые клетки иммунной системы, защищающие организм от инфекций и заболеваний. Уровень лимфоцитов в крови варьируется в зависимости от возраста, что важно учитывать для женщин. В статье рассмотрим нормальные показатели лимфоцитов для различных возрастных групп и представим таблицу с данными. Знание этих норм поможет женщинам выявлять отклонения и обращаться за медицинской помощью при необходимости.
Что такое лимфоциты в крови у женщин?
Лимфоциты представляют собой белые кровяные клетки, играющие ключевую роль в функционировании иммунной системы. Их производство осуществляется в вилочковой железе и лимфоузлах. Каждый день организм человека подвергается атакам вирусов, бактерий и инфекций, и вероятность заболевания зависит от эффективности иммунной системы. Жизненный цикл лимфоцитов может варьироваться от одного месяца до года, однако существуют и такие клетки, которые могут функционировать на протяжении всей жизни.
Лимфоциты делятся на три основные группы, каждая из которых выполняет свою уникальную функцию в организме:
- Т-клетки – составляют от 65 до 80% всех лимфоцитов и отвечают за распознавание чуждых клеток.
- В-лимфоциты (от 8 до 20%) – занимаются уничтожением инородных клеток.
- НК-клетки (5-20%) – выступают в роли защитников, предотвращая образование раковых клеток, их также называют натуральными киллерами.

Врачи отмечают, что уровень лимфоцитов в крови у женщин варьируется в зависимости от возраста и общего состояния здоровья. Нормальные показатели для женщин в возрасте от 18 до 30 лет составляют от 20% до 40% от общего числа лейкоцитов. С возрастом, начиная с 30 лет, этот диапазон может немного изменяться, оставаясь в пределах 19% — 37%. У женщин старше 50 лет нормальные значения могут колебаться от 18% до 34%. Важно учитывать, что на уровень лимфоцитов могут влиять различные факторы, такие как стресс, инфекции и хронические заболевания. Поэтому регулярные медицинские обследования и анализы крови помогают контролировать состояние иммунной системы и своевременно выявлять возможные отклонения. Врачи рекомендуют обращать внимание на изменения в самочувствии и при необходимости консультироваться со специалистами.

Функции
Основная функция лимфоцитов заключается в защите организма человека. Они играют ключевую роль в предотвращении заболеваний и образовании раковых опухолей. Кроме того, лимфоциты активно участвуют в функционировании иммунной системы.
Чтобы определить уровень лимфоцитов в организме, необходимо сдать клинический или расширенный анализ крови. Изменения в их количестве могут указывать на необходимость дополнительных исследований. На основании лейкоцитарной формулы врач ставит диагноз и назначает соответствующее лечение.
Функции лимфоцитов:
- обнаруживают и уничтожают поврежденные и чуждые клетки;
- вырабатывают антитела;
- передают информацию о патогенных клетках следующему поколению;
- ликвидируют клетки с мутациями;
- создают барьер, препятствующий проникновению бактерий в организм;
Интересный факт!
Наивысший уровень лимфоцитов в крови наблюдается у новорожденных и составляет от 45 до 70%.
| Возраст | Норма лимфоцитов (абсолютное число, x10^9/л) | Норма лимфоцитов (относительное число, %) |
|---|---|---|
| Новорожденные (до 1 месяца) | 2.0 — 11.0 | 40 — 70 |
| Дети (1 месяц — 1 год) | 4.0 — 10.5 | 45 — 75 |
| Дети (1 год — 6 лет) | 2.0 — 8.0 | 30 — 60 |
| Дети (6 лет — 12 лет) | 1.5 — 6.5 | 25 — 50 |
| Подростки (12 лет — 18 лет) | 1.0 — 4.8 | 20 — 40 |
| Взрослые женщины (18 лет — 60 лет) | 1.0 — 4.8 | 20 — 40 |
| Пожилые женщины (старше 60 лет) | 0.8 — 4.0 | 18 — 38 |
Норма лимфоцитов у взрослого человека в крови
Нормальные показатели лимфоцитов для взрослого человека, независимо от пола, составляют от 18 до 40%, а в абсолютных значениях — от 1 до 4,5 на 10^9/л. Тем не менее, небольшие отклонения от этих норм обычно не свидетельствуют о наличии заболевания. Легкие изменения уровня лейкоцитов могут быть вызваны следующими факторами:
- стрессом;
- интенсивными физическими нагрузками;
- продолжительным пребыванием на солнце;
- употреблением алкоголя;
- недавними вирусными инфекциями;
- курением;

Норма лимфоцитов в крови у женщин: таблица
Для мужчин и женщин нормы примерно одинаковы, однако женский организм имеет свои особенности. Изменения могут происходить во время менструации или беременности, а также иногда уровень может снижаться в период лактации или при других гормональных изменениях.
Допустимые нормы для женщин в разных возрастных группах представлены в таблице ниже.
| Возраст женщины | Процентное соотношение |
| 0-12 месяцев | 45-69 |
| 12-24 месяца | 35-60 |
| 2-4 года | 33-52 |
| 5-12 лет | 30-49 |
| 12-16 лет | 30-47 |
| 17-21 год | 34-44 |
| Старше 21 года | 20-37 |
Рост уровня лимфоцитов при беременности: причины
Количество лимфоцитов у беременной женщины может варьироваться, и в этом нет повода для беспокойства. В 85% случаев наблюдается снижение этих показателей, что является нормальным явлением в данный период. Если состояние будущей мамы вызывает сомнения, врач может назначить повторные анализы.
Обратите внимание!
Нормальные значения лейкоцитов во время беременности составляют 18-45%.
Увеличение числа лейкоцитов связано с тем, что эмбрион включает не только материнские клетки, но и генетический материал отца. Организм женщины может воспринимать ребенка как инородное тело и, в ответ на это, вырабатывать больше белых кровяных клеток для его защиты.
Как определяется уровень лимфоцитов: подготовка к процедуре
Определить уровень лимфоцитов можно с помощью стандартного анализа крови. Это исследование доступно как в государственных, так и в частных медицинских учреждениях. Ранее медицинские работники вручную подсчитывали количество клеток, наблюдая за образцом под микроскопом, и вычисляли процентное соотношение. В настоящее время для этих целей используются анализаторы, которые автоматически определяют цвет, форму и количество клеток. Чтобы получить максимально точные результаты, необходимо правильно подготовиться к исследованию.
Подготовка к анализам: рекомендации
- Ужин перед процедурой должен быть легким, рекомендуется исключить жирные, жареные и калорийные блюда;
- Кровь следует сдавать на голодный желудок;
- За сутки до процедуры стоит отказаться от алкоголя;
- Курильщикам желательно воздержаться от курения за несколько часов до сдачи анализа;
Причины повышения числа лимфоцитов
Повышение уровня лимфоцитов называется лимфоцитозом и может быть как абсолютным, так и относительным. Кроме факторов, связанных с образом жизни, увеличение лимфоцитов может указывать на наличие патологий в организме.
- бактериальные или вирусные инфекции;
- состояния, сопровождающиеся гнойными выделениями, такие как аппендицит;
- воспалительные процессы в женских половых органах;
- онкологические заболевания;
- инфекционные недуги;
- нарушения функционирования вилочковой железы;
- астматические реакции;
- интоксикация организма;
- аллергические реакции;
Причины снижение числа лимфоцитов
Сниженный уровень лимфоцитов называется лимфопенией и подразделяется на два типа: относительную и абсолютную. Относительная лимфопения может наблюдаться при таких состояниях, как пневмония и лейкемический миелоз. Абсолютная форма может указывать на наличие инфекционных заболеваний, туберкулеза или онкологических процессов.
Приобретенная лимфопения может возникать по следующим причинам:
- неправильное питание;
- инфаркт миокарда;
- инфекции;
- вредные привычки;
- применение определенных медикаментов;
Обратите внимание!
Врожденная лимфопения встречается значительно реже.
Как контролировать уровень лимфоцитов?
Для поддержания нормального уровня лимфоцитов в крови важно придерживаться здорового образа жизни, правильно питаться, избегать чрезмерных физических нагрузок и стрессовых ситуаций. Увеличить количество лимфоцитов в организме помогут:
- белковые продукты;
- продукты, богатые витамином С (апельсины, лимоны, малина, черная смородина);
- качественный зеленый чай;
- достаточное количество очищенной питьевой воды;
Чтобы снизить уровень лимфоцитов в крови, рекомендуется изменить рацион, включая в него: растительные белковые продукты, оливковое масло и продукты, содержащие полезные жиры.
Лечение
Как понижение, так и повышение количества лимфоцитов в крови могут служить лишь признаком какого-либо заболевания. Поэтому в первую очередь необходимо определить причину, по которой показатели изменились, а затем уже начинать лечение.
Лечение направлено на устранение основного заболевания.
Точный диагноз и адекватное лечение может установить только квалифицированный специалист.
Заключение
Незначительные изменения в уровне лимфоцитов обычно не указывают на наличие заболеваний. Чаще всего это связано с образом жизни или физиологическими особенностями женского организма. Однако при значительном повышении или понижении этих показателей важно пройти полное обследование, чтобы своевременно обнаружить и устранить возможные болезни.
Влияние образа жизни на уровень лимфоцитов
Уровень лимфоцитов в крови может значительно варьироваться в зависимости от образа жизни женщины. Факторы, такие как питание, физическая активность, стресс и качество сна, оказывают непосредственное влияние на иммунную систему и, соответственно, на количество лимфоцитов.
Правильное питание играет ключевую роль в поддержании нормального уровня лимфоцитов. Диета, богатая витаминами и минералами, особенно витаминами C, D и E, а также цинком и селеном, способствует укреплению иммунной системы. Продукты, содержащие антиоксиданты, такие как фрукты и овощи, помогают защитить клетки от повреждений и поддерживают нормальную функцию лимфоцитов.
Физическая активность также имеет значительное влияние на уровень лимфоцитов. Регулярные умеренные физические нагрузки способствуют улучшению циркуляции крови и активизации иммунной системы. Однако чрезмерные физические нагрузки могут привести к истощению организма и снижению уровня лимфоцитов, что делает важным соблюдение баланса между активностью и отдыхом.
Стресс является еще одним важным фактором, который может негативно сказаться на уровне лимфоцитов. Хронический стресс приводит к повышению уровня кортизола, что может подавлять иммунный ответ и снижать количество лимфоцитов. Практики управления стрессом, такие как медитация, йога и дыхательные упражнения, могут помочь поддерживать нормальный уровень лимфоцитов.
Качество сна также играет важную роль в поддержании здоровья иммунной системы. Недостаток сна или его плохое качество могут привести к снижению уровня лимфоцитов и ухудшению общего состояния здоровья. Рекомендуется стремиться к 7-9 часам качественного сна каждую ночь для оптимального функционирования иммунной системы.
Таким образом, образ жизни женщины, включая питание, физическую активность, управление стрессом и качество сна, оказывает значительное влияние на уровень лимфоцитов в крови. Поддержание здорового образа жизни может помочь сохранить нормальные показатели лимфоцитов и, как следствие, укрепить иммунную систему.
Роль питания в поддержании нормального уровня лимфоцитов
Питание играет ключевую роль в поддержании нормального уровня лимфоцитов в крови, так как именно от него зависит общее состояние иммунной системы. Лимфоциты, являясь важной частью иммунной системы, отвечают за защиту организма от инфекций и заболеваний. Поэтому важно обеспечить организм всеми необходимыми питательными веществами для поддержания их оптимального уровня.
Во-первых, белки являются основным строительным материалом для клеток, включая лимфоциты. Источники белка, такие как мясо, рыба, яйца, бобовые и молочные продукты, должны быть включены в рацион. Особенно важны белки, содержащие аминокислоты, такие как лейцин, которые способствуют синтезу лимфоцитов.
Во-вторых, витамины и минералы играют важную роль в поддержании нормального уровня лимфоцитов. Витамины группы B, особенно B6 и B12, необходимы для нормального функционирования иммунной системы. Витамин C, содержащийся в цитрусовых, ягодах и овощах, способствует повышению активности лимфоцитов и защищает их от окислительного стресса. Витамин D, который можно получить из солнечного света и некоторых продуктов, также важен для регуляции иммунного ответа.
Кроме того, минералы, такие как цинк и селен, играют важную роль в поддержании нормального уровня лимфоцитов. Цинк, содержащийся в мясе, орехах и семенах, необходим для созревания и активации лимфоцитов. Селен, который можно найти в рыбе, орехах и цельнозерновых продуктах, также способствует поддержанию иммунной функции.
Не менее важным аспектом является потребление антиоксидантов, которые помогают защищать клетки иммунной системы от повреждений. Фрукты и овощи, особенно яркие и насыщенные цветом, такие как морковь, шпинат, ягоды и брокколи, богаты антиоксидантами и должны составлять основу рациона.
Также стоит обратить внимание на достаточное потребление жидкости. Обезвоживание может негативно сказаться на состоянии крови и, соответственно, на уровне лимфоцитов. Рекомендуется пить достаточное количество воды, а также включать в рацион жидкости, богатые электролитами, такие как кокосовая вода или натуральные соки.
Наконец, важно избегать избыточного потребления сахара и обработанных продуктов, которые могут негативно влиять на иммунную систему и уровень лимфоцитов. Сбалансированное питание, состоящее из натуральных и разнообразных продуктов, поможет поддерживать нормальный уровень лимфоцитов и общее здоровье организма.
Когда обращаться к врачу: симптомы и признаки отклонений
Лимфоциты – это один из основных типов белых кровяных клеток, играющих ключевую роль в иммунной системе человека. Они отвечают за защиту организма от инфекций и болезней. Нормальный уровень лимфоцитов в крови может варьироваться в зависимости от возраста, пола и состояния здоровья. У женщин, как и у мужчин, уровень лимфоцитов может изменяться под воздействием различных факторов, включая гормональные изменения, стресс, инфекции и хронические заболевания.
Существует несколько симптомов и признаков, которые могут указывать на отклонения в уровне лимфоцитов. Если уровень лимфоцитов слишком низкий (лимфопения), это может проявляться в виде частых инфекций, усталости, слабости, а также в виде увеличения лимфатических узлов. Наоборот, повышенный уровень лимфоцитов (лимфоцитоз) может быть связан с инфекциями, воспалительными процессами или даже некоторыми видами рака. Симптомы, такие как лихорадка, потливость, потеря веса и общая слабость, также могут указывать на необходимость обращения к врачу.
Важно помнить, что уровень лимфоцитов может колебаться в течение дня и зависеть от различных факторов, таких как физическая активность, эмоциональное состояние и даже время суток. Поэтому для точной диагностики и определения причин отклонений от нормы необходимо проводить анализы крови в условиях лаборатории и учитывать все сопутствующие симптомы.
Если женщина замечает у себя необычные симптомы, такие как постоянная усталость, частые инфекции или другие изменения в самочувствии, ей следует обратиться к врачу для проведения комплексного обследования. Врач может назначить дополнительные анализы и исследования, чтобы выяснить причину отклонений в уровне лимфоцитов и, при необходимости, назначить соответствующее лечение.